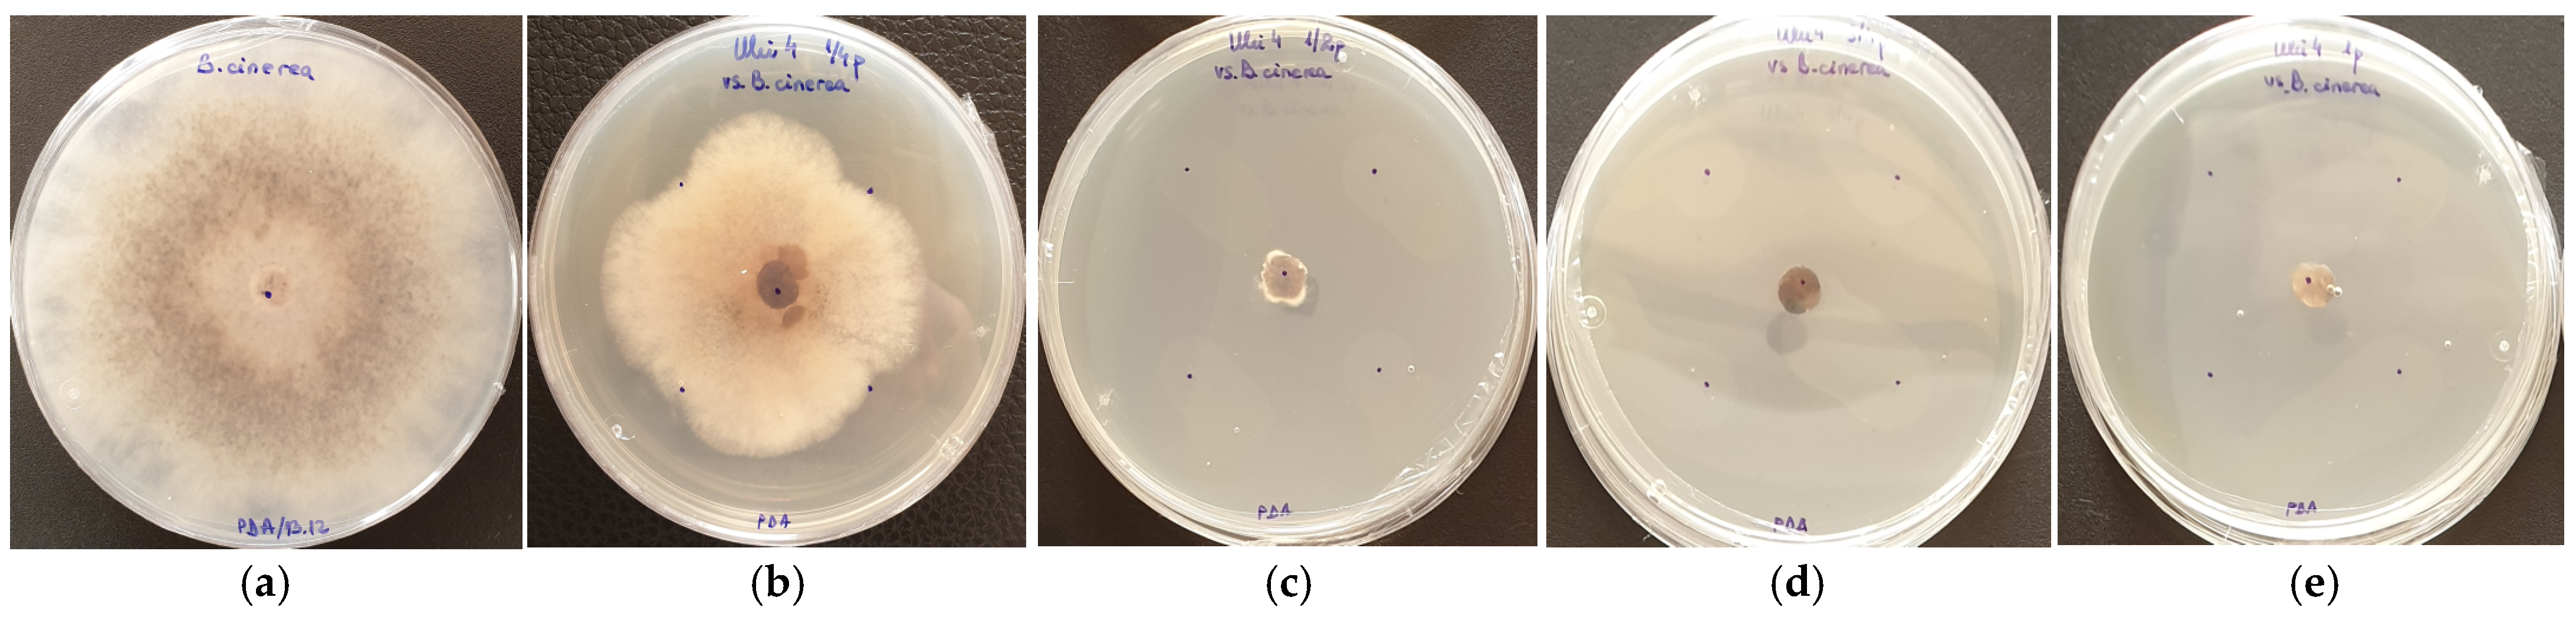
Applsci 14 03159 g008

Pesticidal Potential of Essential Oil Obtained from a New Variety of Marigold (Tagetes patula L., fam. Asteraceae)
Abstract
1. Introduction
2. Materials and Methods
2.1. Experimental Cultures and Plant Samples
2.2. The Extraction Process of Essential Oils and Floral Waters
2.3. Evaluation of Essential Oils and Floral Waters
2.4. Evaluation of the EO and FW Antioxidant Activity
- A.
- The scavenger activity of the DPPH radical (2,2-diphenyl-1-picrylhydrazyl) is based on the ability of antioxidants to reduce the DPPH radical. The rate of DPPH remaining in the solution is determined using Formula (2):
- B.
- The scavenger activity of the ABTS radical (2,2′-azinobis (3-ethylbenzothiazoline-6-sulfonic acid)): Because the expression of the extract antioxidant capacity can be related to Trolox equivalents, the technique is known as TEAC (Trolox equivalent antioxidant capacity). Three Trolox standard calibration curves were used to express the antioxidant capacity in milligrams (mg) of Trolox.
- C.
- Ferric ion reducing antioxidant power (FRAP): This relies on the capacity of antioxidants to reduce the yellow-colored tripyridyltriazine Fe3+ (Fe (III)-TPTZ) complex to the blue-colored tripyridyltriazine Fe2+ (Fe (II)-TPTZ) complex by the action of electron release by antioxidants. The evaluations were tested in triplicate, and the FRAP values of each sample were expressed in mM Trolox g-1 for EOs and L-1h for FWs.
2.5. Evaluation of Microbial Strains and Growth Conditions
2.6. Assessment of Essential Oil Emulsions
2.7. Antibacterial Assay
2.8. Antifungal Assay
2.9. Insecticidal Assay
2.10. Statistical Processing of Experimental Data
3. Results
3.1. EO and FW Chemical Composition Evaluation with GC/MS
3.2. Antioxidant Activity of the EOs and FWs
3.3. Antibacterial Activity of the EO
3.4. Antifungal Activity of the EO
3.5. Insecticidal Activity of the EO
4. Discussion
4.1. EO and FW Chemical Composition Evaluation
4.2. Antioxidant Activity of the EOs and FWs
4.3. Antibacterial and Antifungal Activity of the EO of Marigold
4.4. Insecticidal Activity of the EO of Marigold
5. Conclusions
Author Contributions
Funding
Institutional Review Board Statement
Informed Consent Statement
Data Availability Statement
Conflicts of Interest
Abbreviations
References
- Burt, S. Essential oils: Their antibacterial properties and potential applications in foods—A review. Int. J. Food Microbiol. 2004, 94, 223–253. [Google Scholar] [CrossRef] [PubMed]
- Prieto, M.C.; Camacho, N.M.; Inocenti, F.D.; Mignolli, F.; Lucini, E.; Palma, S.; Bima, P.; Grosso, N.R.; Asensio, C.M. Microencapsulation of Thymus vulgaris and Tagetes minuta essential oils: Volatile release behavior, antibacterial activity and effect on potato yield. J. Saudi Soc. Agric. Sci. 2023, 3, 195–204. [Google Scholar] [CrossRef]
- Prieto, M.C.; Lapaz, M.I.; Lucini, E.I.; Pianzzola, M.J.; Grosso, N.R.; Asensio, C.M. Thyme and suico essential oils: Promising natural tools for potato common scab control. Plant Biol. 2020, 22, 81–89. [Google Scholar] [CrossRef] [PubMed]
- Hajian-Maleki, H.; Baghaee-Ravari, S.; Moghaddam, M. Herbal essential oils exert a preservative effect against the potato soft rot disease. Sci. Hortic. 2021, 285, 110192. [Google Scholar] [CrossRef]
- Isman, M.B. Plant essential oils for pest and disease management. Crop Prot. 2000, 19, 603–608. [Google Scholar] [CrossRef]
- Asensio, C.M.; Paredes, A.J.; Martin, M.P.; Alemandi, D.A.; Nepote, V.; Grosso, N.R. Antioxidant stability study of oregano essential oil microcapsules prepared by spray-drying. J. Food Sci. 2017, 82, 2864–2872. [Google Scholar] [CrossRef]
- Ayala-Zavala, J.F.; Soto-Valdez, H.; Gonzáles-León, A.; Alvarez-Parrilla, E.; Martin Belloso, O.; Gonzalez-Aguilar, G.A. Microencapsulation of cinnamon leaf (Cinnamomum zeylanicum) and garlic (Allium sativum) oils in beta-cyclodextrin. J. Incl. Phenom. Macrocycl. Chem. 2008, 60, 359–368. [Google Scholar] [CrossRef]
- Alipour, M.; Saharkhiz, M.J.; Niakousari, M.; Damyeh, M.S. Phytotoxicity of encapsulated essential oil of rosemary on germination and morphophysiological features of amaranth and radish seedlings. Sci. Hortic. 2019, 243, 131–139. [Google Scholar] [CrossRef]
- Taban, A.; Saharkhiz, M.J.; Kavoosi, G. Development of pre-emergence herbicide based on Arabic gum-gelatin, apple pectin and savory essential oil nano-particles: A potential green alternative to metribuzin. Int. J. Biol. Macromol. 2021, 167, 756–765. [Google Scholar] [CrossRef]
- Wanjal, W.C.; Wanzala, W. Chapter 90-Tagetes (Tagetes minuta) oils. In Essential Oils in Food Preservation, Flavor and Safety; Academic Press: London, UK, 2016. [Google Scholar]
- Salehi, B.; Valussi, M.; Bezerra Morais-Braga, M.F.; Pereira, C.J.N.; Borges Leal, A.L.A.; Melo Coutinho, H.D.; Vitalini, S.; Kregiel, D.; Antolak, H.; Sharifi-Rad, M.; et al. Tagetes spp. Essential Oils and other extracts: Chemical Characterization and Biological Activity. Molecules 2018, 23, 2847. [Google Scholar] [CrossRef]
- Gakuubi, M.M.; Wanzala, W.; Wagacha, J.M.; Dossaji, S.F. Bioactive properties of Tagetes minuta L. (Asteraceae) essential oils: A review. AJONP Am. J. Essent. Oils Nat. Prod. 2016, 4, 27–36. [Google Scholar]
- Fabrick, J.A.; Yool, A.J.; Spurgeon, D.W. Insecticidal activity of marigold Tagetes patula plants and foliar extracts against the hemipteran pests, Lygus hesperus and Bemisia tabaci. PLoS ONE 2020, 15, e0233511. [Google Scholar] [CrossRef] [PubMed]
- Ravikumar, P. Chemical examination and insecticidal properties of Tagetes erecta and Tagetes patula. Asian J. Biol. Sci. 2010, 5, 29–31. [Google Scholar]
- Safar, A.A.; Anwar Othman Ghafoor, A.O.; Dastan, D. Screening of chemical characterization, antifungal and cytotoxic activities of essential oil constituents of Tagetes erecta L. from Erbil, Kurdistan Region-Iraq. Pol. J. Environ. Stud. 2020, 29, 2317–2326. [Google Scholar] [CrossRef]
- Bakshi, L.; Gosh, R. Marigold biopesticide as an alternative to conventional chemical pesticides. J. Adv. Sci. Res. 2022, 13, 26–33. [Google Scholar] [CrossRef]
- Wright, P.J.; Hale, C.N. A field and storage rot of onion caused by Pseudomonas marginalis. N. Z. J. Crop Hortic. Sci. 1992, 20, 435–438. [Google Scholar] [CrossRef]
- Krejzar, V.; Mertelík, J.; Pánková, I. Pseudomonas marginalis Associated with Soft Rot of Zantedeschia spp. Plant Prot. Sci. 2008, 44, 85–90. [Google Scholar] [CrossRef]
- Kůdela, V.; Krejzar, V.; Pánková, I. Pseudomonas corrugata and Pseudomonas marginalis associated with the collapse of tomato plants in Rockwool slab hydroponic culture. Plant Protect. Sci. 2010, 46, 1–11. [Google Scholar] [CrossRef]
- Xin, X.F.; Kvitko, B.; He, S.Y. Pseudomonas syringae: What it takes to be a pathogen. Nature reviews. Microbiology 2018, 16, 316–328. [Google Scholar] [CrossRef]
- Boyraz, N.; Bastas, K.K.; Maden, S.; Yasar, A. Bacterial leaf and peduncle soft rot caused by Pectobacterium carotovorum on tulips in Konya, Turkey. Phytoparas 2006, 34, 272–280. [Google Scholar] [CrossRef]
- Raymond, G.A.T.; Roland, T.V.F. Diseases of Temperate Horticultural Plants; CAB International: New York, NY, USA, 2014; 488p. [Google Scholar]
- Lahlali, R.; Hijri, M. Screening, identification and evaluation of potential biocontrol fungal endophytes against Rhizoctonia solani AG3 on potato plants. FEMS Microbiol. Lett. 2010, 311, 152–159. [Google Scholar] [CrossRef] [PubMed]
- Stan (Tudora), C.; Neneciu, F.; Muscalu, A.; Vladut, V.N.; Burnichi, F.; Popescu, C.; Gatea, F.; Boiu-Sicuia, O.A.; Israel-Roming, F. Chemical composition, antioxidant and antimicrobial effects of essential oils extracted from two new Ocimum basilicum L. varietes. Diversity 2022, 14, 1048. [Google Scholar] [CrossRef]
- Chouhan, S.; Sharma, K.; Guleria, S. Antimicrobial Activity of Some Essential Oils-Present Status and Future Perspectives. Medicines 2017, 4, 58. [Google Scholar] [CrossRef] [PubMed]
- Koul, O.; Suresh, W.; Dhaliwal, G.S. Essential oils as green pesticides: Potential and constraints. Biopest. Intern. 2008, 4, 63–84. [Google Scholar]
- Salachna, P.; Łopusiewicz, Ł.; Wesołowska, A.; Meller, E.; Piechocki, R. Mushroom waste biomass alters the yield, total phenolic content, antioxidant activity and essential oil composition of Tagetes patula L. Inds. Crops Prod. 2021, 171, 113961. [Google Scholar] [CrossRef]
- Abbas, A.; Tabanka, N.; Amin, E.; Demirci, B.; Khan, I.A. Chemical composition and biting deterrent activity essential oil of Tagetes patula (Marigold) against Aedes aegypti. NPC Nat. Prod. Commun. 2016, 11, 1535–1538. [Google Scholar] [CrossRef]
- Politi, F.A.; De Souza-Moreira, T.M.; Rodrigues, E.R.; De Queiroz, G.M.; Figueira, G.M.; Januario, A.H.; Berenger, J.M.; Socolovschi, C.; Parola, P.; Pietro, R.C. Chemical characterization and acaricide potential of essential oil from aerial parts of Tagetes patula L. (Asteraceae) against engorged adult females of Rhipicephalus sanguineus (Latreille, 1806). Parasit. Res. 2013, 12, 2261–2268. [Google Scholar] [CrossRef] [PubMed]
- Safar, A.A.; Ghafoor, A.O.; Dastan, D. Chemical composition, antibacterial and antioxidant activities of Tagetes patula L. essential oil raised in Erbil, Iraq. J. Rep. Pharm. Sci. 2020, 9, 59–67. [Google Scholar] [CrossRef]
- Singh, P.; Krishna, A.; Kumar, V.; Krishna, S.; Singh, K.; Gupta, M.; Singh, S. Chemistry and biology of industrial crop Tagetes species: A review. J. Essent. Oil Res. 2015, 28, 1–14. [Google Scholar] [CrossRef]
- Marotti, M.; Piccaglia, R.; Biavati, B.; Marotti, I. Characterization and yield evaluation of essential oils from different Tagetes species. J. Essent. Oil Res. 2004, 16, 440–444. [Google Scholar] [CrossRef]
- Shetty, L.J.; Sakr, M.F.; Al-Obaidy, K.; Patel, J.M.; Shareef, H. A brief review on medicinal plant Tagetes erecta Linn. J. Appl. Pharm. Sci. 2015, 5, 91–95. [Google Scholar] [CrossRef]
- Isiaka, A.O.; Nureni, O. The essential oil from the leaves and flowers of ‘African Marigold’, Tagetes erecta L. J. Essent. Oil Res. 2006, 18, 366–368. [Google Scholar] [CrossRef]
- Cerrón-Mercado, F.; Perez-Alvarez, J.A.; Nolazco-Cama, D.; Salva-Ruíz, B.; Tellez-Monzon, L.; Fernández-López, J.; Viuda-Martos, M. Chemical Composition, Antioxidant and Antibacterial Activities of Essential Oil Obtained from Chincho (Tagetes elliptica) Leaves Grown in the Peruvian Andes. Foods 2023, 12, 894. [Google Scholar] [CrossRef] [PubMed]
- Barra, A. Factors Affecting Chemical Variability of Essential Oils: A Review of Recent Developments. Nat. Prod. Commun. 2009, 4, 1147–1154. [Google Scholar] [CrossRef] [PubMed]
- Zielińska-Błajet, M.; Feder-Kubis, J. Monoterpenes and their derivatives-recent development in biological and medical applications. Int. J. Mol. Sci. 2020, 21, 7078. [Google Scholar] [CrossRef] [PubMed]
- Jugreet, B.S.; Suroowan, S.; Rengasamy, R.R.K.; Mahomoodally, M.F. Chemistry, bioactivities, mode of action and industrial applications of essential oils. Trends Food Sci. Technol. 2020, 101, 89–105. [Google Scholar] [CrossRef]
- Bakkali, F.; Averbeck, S.; Averbeck, D.; Idaomar, M. Biological effects of essential oils-A review. Food Chem. Toxicol. 2008, 46, 446–475. [Google Scholar] [CrossRef] [PubMed]
- Mazzanti, G.; Battinelli, L.; Salvatore, G. Antimicrobial properties of the linalol-rich essential oil of Hyssopus officinalis L. var decumbens (Lamiaceae). Flavour Fragr. J. 1998, 13, 289–294. [Google Scholar] [CrossRef]
- Romagnoli, C.; Bruni, R.; Andreotti, E.; Rai, M.K.; Vicentini, C.B.; Mares, D. Chemical characterization and antifungal activity of essential oil of capitula from wild indian Tagetes patula L. Protoplasma 2005, 225, 57–65. [Google Scholar] [CrossRef]
- Thembo, K.M.; Vismer, H.F.; Nyazema, N.Z.; Gelderblom, W.C.; Katerere, D.R. Antifungal activity of four weedy plant extracts against selected mycotoxigenic fungi. J. Appl. Microbiol. 2010, 109, 1479–1486. [Google Scholar] [CrossRef]
- Santos, D.C.D.; Schneider, L.R.; da Silva Barboza, A.; Diniz Campos, Â.; Lund, R.G. Systematic review and technological overview of the antimicrobial activity of Tagetes minuta and future perspectives. J. Ethnopharmacol. 2017, 208, 8–15. [Google Scholar] [CrossRef] [PubMed]
- Zoubiri, S.; Baaliouamer, A. Potentiality of plants as source of insecticide principles. J. Saudi Chem. Soc. 2014, 18, 925–938. [Google Scholar] [CrossRef]
- Singh, G.; Singh, O.P.; De Lampasona, M.P.; Catalán, C.A.N. Studies on essential oils. Part 35: Chemical and biocidal investigations on Tagetes erecta leaf volatile oil. Flavour Fragr. J. 2003, 18, 62–65. [Google Scholar] [CrossRef]
- Laznik, Z.; Vidrih, M.; Trdan, S. Efficacy of four essential oils against Sitophilus granarius (L.) adults after short-term exposure. Afr. J. Agric. Res. 2012, 7, 3175–3181. [Google Scholar] [CrossRef]
- Nerio, L.S.; Olivero-Verbel, J.; Stashenko, E.E. Repellent activity of essential oils from seven aromatic plants grown in Colombia against Sitophilus zeamais Motschulsky (Coleoptera). J. Stored Prod. Res. 2009, 45, 212–214. [Google Scholar] [CrossRef]

| Compound Name | Molecular Formula | RI | 2018 * (Area %) | 2019 * (Area %) | 2020 * (Area %) |
|---|---|---|---|---|---|
| D-Limonene | C10H16 | 14.01 | 4.42 | 5.35 | 7.83 |
| β-Ocimene | C10H16 | 15.99 | 5.28 | 5.57 | 11.73 |
| Carene | C10H16 | 17.54 | 9.93 | 11.21 | 15.45 |
| Oxirane | C2H4O | 23.51 | 3.02 | nd | 6.25 |
| β-Pinocamphone | C10H16O | 24.63 | 3.73 | nd | nd |
| Ciclohexene methanol | C7H14O | 24.66 | 3.08 | nd | 3.13 |
| cis-Tagetone | C10H16O | 24.71 | nd | nd | 2.41 |
| trans-Tagetone | C10H16O | 25.13 | nd | 2.71 | 4.61 |
| α-Pinocamphone | C10H16O | 25.38 | 7.90 | nd | nd |
| Linalool | C10H18O | 26.02 | nd | 4.27 | 2.34 |
| Azulene | C10H8 | 26.93 | nd | 3.10 | nd |
| Caryophyllene | C15H24 | 26.74 | 12.69 | 13.38 | 3.45 |
| Estragole | C10H12O | 28.98 | nd | 13.58 | 4.09 |
| cis-Verbenone | C10H14O | 29.13 | 5.44 | 4.23 | nd |
| Germacrene | C15H24 | 29.44 | 6.12 | 6.97 | nd |
| trans-Verbenone | C10H14O | 29.58 | 10.18 | nd | 9.81 |
| Eudesmadiene | C15H24 | 30.89 | nd | 3.09 | nd |
| Piperitone | C10H16O | 29.86 | 3.77 | 9.01 | 1.36 |
| Elemene | C15H24 | 30.00 | 4.20 | 2.53 | 3.05 |
| Berbenone | C10H14O | 34.27 | 9.37 | nd | nd |
| Piperitenone | C10H14O | 34.07 | 8.49 | 6.56 | 8.73 |
| 3-Eicosyne | C20H38 | 34.55 | nd | 4.55 | nd |
| Phytol | C20H40O | 35.00 | nd | nd | 1.48 |
| Elemol | C15H26O | 37.22 | 2.38 | nd | nd |
| Cadinol | C15H26O | 39.30 | nd | 4.88 | 1.28 |
| Total of major compounds | 25 compounds identified, representing over 99.99% | ||||
| Classes | |||||
| Monoterpene hydrocarbons | 19.63 | 25.23 | 35.01 | ||
| Oxygenated monoterpenes | 48.87 | 40.36 | 46.34 | ||
| Monoterpenes | 68.50 | 65.59 | 81.35 | ||
| Sesquiterpene hydrocarbons | 23.01 | 24.97 | 6.50 | ||
| Oxygenated sesquiterpenes | 2.38 | 4.88 | 1.28 | ||
| Sesquiterpenes | 25.39 | 29.85 | 7.78 | ||
| Diterpene hydrocarbons | 0 | 4.55 | 0 | ||
| Oxygenated diterpenes | 0 | 0 | 1.48 | ||
| Diterpenes | 0 | 4.55 | 1.48 | ||
| Others | 6.10 | 0 | 9.38 | ||
| Compound Name | Molecular Formula | RI | 2018 * (Area %) | 2019 * (Area %) | 2020 * (Area %) |
|---|---|---|---|---|---|
| D-Limonene | C10H16 | 14.43 | nd | 4.33 | nd |
| α-Pinene | C10H16 | 16.40 | nd | 4.28 | nd |
| α-Terpineol | C10H18O | 17.55 | 1.16 | 7.84 | nd |
| Oxirane | C2H4O | 23.52 | 1.54 | nd | nd |
| cis-Tagetone | C10H16O | 24.61 | 1.34 | 1.72 | 0.99 |
| trans-Pinocamphone | C10H16O | 24.64 | 2.00 | nd | nd |
| trans-Tagetone | C10H16O | 24.78 | 1.35 | 2.63 | 1.24 |
| cis-Pinocamphone | C10H16O | 25.40 | 4.56 | nd | nd |
| Linalool | C10H18O | 26.03 | 1.45 | 2.23 | 1.78 |
| Terpinen-4-ol | C10H18O | 27.24 | nd | nd | 0.69 |
| Azulene | C10H8 | 26.94 | nd | 3.40 | nd |
| Caryophyllene | C15H24 | 26.75 | 2.34 | 12.10 | nd |
| Estragole | C10H12O | 28.98 | nd | 11.64 | 0.67 |
| Germacrene | C15H24 | 29.76 | nd | 6.61 | nd |
| Citral | C10H16O | 29.97 | 2.11 | nd | 2.39 |
| cis-Verbenone | C10H14O | 29.52 | 4.87 | 4.29 | 6.48 |
| Borneole | C10H18O | 29.55 | nd | nd | 0.73 |
| trans-Verbenone | C10H14O | 29.59 | 5.43 | nd | 8.19 |
| α-Humulene | C15H24 | 29.91 | nd | 3.17 | nd |
| Piperitone | C10H16O | 30.16 | 14.18 | 2.90 | 10.96 |
| Cadinenes | C15H24 | 30.26 | nd | 4.89 | nd |
| Eudesmadiene | C15H24 | 30.97 | nd | 2.00 | nd |
| Elemene | C15H24 | 30.91 | nd | 3.31 | nd |
| Phenylethyl acetate | C10H12O | 32.19 | nd | nd | 0.95 |
| Carvone | C10H14O | 32.68 | nd | nd | 0.79 |
| Thymol | C10H14O | 32.88 | 1.20 | nd | 0.70 |
| Piperitenone | C10H16O | 34.08 | 50.94 | 9.84 | 60.19 |
| 3-Eicosyne | C20H38 | 34.57 | nd | 5.23 | nd |
| Phytol | C20H40O | 34.28 | 1.67 | nd | nd |
| Xylenol | C8H10O | 35.13 | nd | nd | 1.53 |
| Cadinol | C15H26O | 39.31 | nd | 5.53 | nd |
| Acetyl cresol | C9H10O2 | 39.45 | 3.86 | nd | nd |
| Hydroxy-methylacetophenone | C9H10O2 | 39.78 | 1.72 | nd | 1.72 |
| Ethanone | C2H2O | 39.89 | nd | 2.06 | nd |
| Total of major compounds | 34 compounds identified, representing 100% | ||||
| Classes | |||||
| Monoterpene hydrocarbons | 0 | 12.01 | 0 | ||
| Oxygenated monoterpenes | 90.59 | 43.09 | 95.80 | ||
| Monoterpenes | 90.59 | 55.10 | 95.80 | ||
| Sesquiterpene hydrocarbons | 2.34 | 32.08 | 0 | ||
| Oxygenated sesquiterpenes | 0 | 5.53 | 0 | ||
| Sesquiterpenes | 2.34 | 37.61 | 0 | ||
| Diterpene hydrocarbons | 0 | 5.23 | 0 | ||
| Oxygenated diterpenes | 1.67 | 0 | 0 | ||
| Diterpenes | 1.67 | 5.23 | 0 | ||
| Others | 5.40 | 2.06 | 4.20 | ||
| Methods | EOs * | FWs * | ||||
|---|---|---|---|---|---|---|
| 2018 | 2019 | 2020 | 2018 | 2019 | 2020 | |
| DPPH a (IC50 L−1) | 0.20 ± 0.00 | 0.61 ± 0.02 | 0.72 ± 0.02 | 352.76 ± 2.21 | 125.50 ± 0.14 | 754.87 ± 2.19 |
| ABTS a (mM Trolox g−1) | 0.09 ± 0.01 | 0.24 ± 0.01 | 0.17 ± 0.00 | 0.96 ± 0.02 | 1.58 ± 0.30 | 0.27 ± 0.06 |
| FRAP (mM Trolox g−1) | 10.51 ± 0.27 | 42.05 ± 3.88 | 35.04 ± 2.18 | 0.05 ± 0.01 | 0.32 ± 0.00 | 0.08 ± 0.00 |
| Sample | Concentration | Inhibition Diameter (cm) | |
|---|---|---|---|
| % | 24 h | 7 Days | |
| Control sample | - | 0 | 0 |
| Marigold EO, “Nanuk” variety | 100 | 1.30 | 1.08 |
| 75 | 1.28 | 1.13 | |
| 50 | 1.05 | 1.00 | |
| 25 | 0.83 | 0.73 | |
| Sample | Concentration | Inhibition Diameter (cm) | |
|---|---|---|---|
| % | 24 h | 7 Days | |
| Control sample | - | 0 | 0 |
| Marigold EO, “Nanuk” variety | 100 | 0.80 | The bacteria were not influenced by the EO anymore, and small isolated colonies were identified. |
| 75 | 0.75 | ||
| 50 | 0.55 | ||
| 25 | 0.53 | ||
| Sample | Concentration | Inhibition Diameter (cm) | |
|---|---|---|---|
| % | 24 h | 7 Days | |
| Control sample | - | 0 | 0 |
| Marigold EO, “Nanuk” variety | 100 | 0.50 | The bacteria were not influenced by the EO anymore, and small isolated colonies were identified. |
| 75 | 0.40 | ||
| 50 | 0.30 | ||
| 25 | 0.24 | ||
| Sample | Concentration | Inhibition Diameter (cm) | Efficiency | |||
|---|---|---|---|---|---|---|
| % | 3 Days | 5 Days | 7 Days | 10 Days | % | |
| Control sample | 0 | 3.90 | 3.90 | 3.90 | 3.90 | / |
| Marigold EO, “Nanuk” variety | 100 | 0 | 0.03 | 0.13 | 0.88 | 77.58 |
| 75 | 0 | 0.18 | 0.43 | 1.68 | 57.00 | |
| 50 | 0.23 | 2.05 | 3.48 | 3.90 | 0 | |
| 25 | 1.80 | 3.40 | 3.90 | 3.90 | 0 | |
| Sample | Concentration | Inhibition Diameter (cm) | Efficiency | |||
|---|---|---|---|---|---|---|
| % | 3 Days | 5 Days | 7 Days | 10 Days | % | |
| Control sample | 0 | 1.23 | 2.42 | 3.20 | 4.12 | / |
| Marigold EO, “Nanuk” variety | 100 | 0.12 | 0.10 | 0.45 | 1.05 | 74.51 |
| 75 | 0.10 | 0.50 | 1.00 | 1.80 | 56.31 | |
| 50 | 0.20 | 0.70 | 1.50 | 2.17 | 47.33 | |
| 25 | 0.75 | 1.60 | 2.37 | 3.25 | 21.12 | |
| Sample | Concentration | Inhibition Diameter (cm) | Efficiency | |||
|---|---|---|---|---|---|---|
| % | 3 Days | 5 Days | 7 Days | 10 Days | % | |
| Control sample | 0 | 1.40 | 2.60 | 3.45 | 3.80 | / |
| Marigold EO, “Nanuk” variety | 100 | 0 | 0 | 0 | 0 | 100 |
| 75 | 0 | 0 | 0 | 0 | 100 | |
| 50 | 0 | 0 | 0 | 0.35 | 90.79 | |
| 25 | 0 | 0.44 | 1.24 | 2.14 | 43.75 | |
Disclaimer/Publisher’s Note: The statements, opinions and data contained in all publications are solely those of the individual author(s) and contributor(s) and not of MDPI and/or the editor(s). MDPI and/or the editor(s) disclaim responsibility for any injury to people or property resulting from any ideas, methods, instructions or products referred to in the content. |
© 2024 by the authors. Licensee MDPI, Basel, Switzerland. This article is an open access article distributed under the terms and conditions of the Creative Commons Attribution (CC BY) license (https://creativecommons.org/licenses/by/4.0/).
Share and Cite
Tudora, C.; Nenciu, F.; Muscalu, A.; Burnichi, F.; Gatea, F.; Boiu-Sicuia, O.A.; Israel-Roming, F. Pesticidal Potential of Essential Oil Obtained from a New Variety of Marigold (Tagetes patula L., fam. Asteraceae). Appl. Sci. 2024, 14, 3159. https://doi.org/10.3390/app14083159
Tudora C, Nenciu F, Muscalu A, Burnichi F, Gatea F, Boiu-Sicuia OA, Israel-Roming F. Pesticidal Potential of Essential Oil Obtained from a New Variety of Marigold (Tagetes patula L., fam. Asteraceae). Applied Sciences. 2024; 14(8):3159. https://doi.org/10.3390/app14083159
Chicago/Turabian StyleTudora, Catalina, Florin Nenciu, Adriana Muscalu, Floarea Burnichi, Florentina Gatea, Oana Alina Boiu-Sicuia, and Florentina Israel-Roming. 2024. "Pesticidal Potential of Essential Oil Obtained from a New Variety of Marigold (Tagetes patula L., fam. Asteraceae)" Applied Sciences 14, no. 8: 3159. https://doi.org/10.3390/app14083159
APA StyleTudora, C., Nenciu, F., Muscalu, A., Burnichi, F., Gatea, F., Boiu-Sicuia, O. A., & Israel-Roming, F. (2024). Pesticidal Potential of Essential Oil Obtained from a New Variety of Marigold (Tagetes patula L., fam. Asteraceae). Applied Sciences, 14(8), 3159. https://doi.org/10.3390/app14083159

